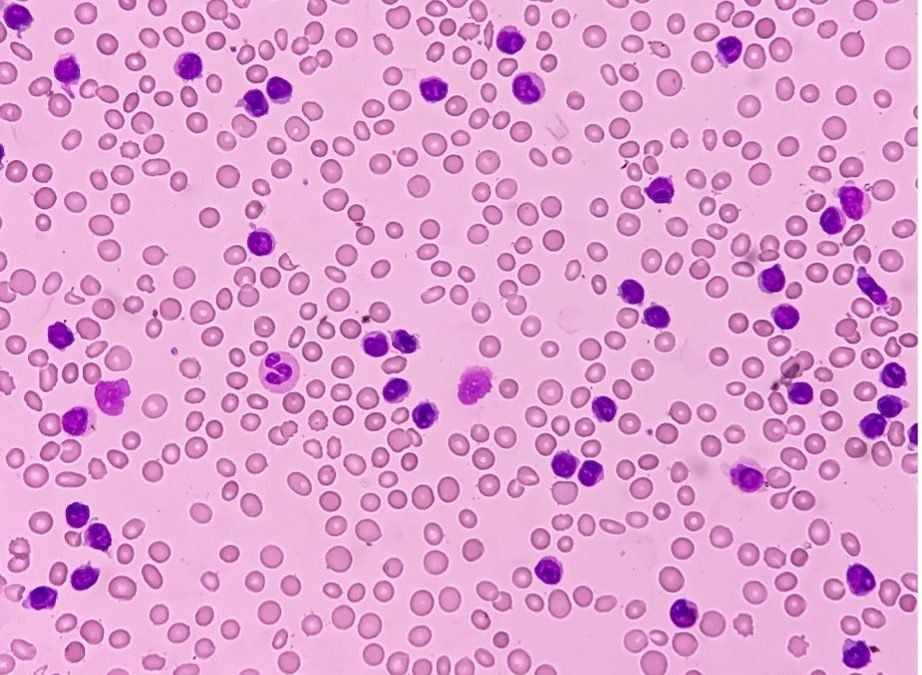

Written by Sarah Locknar
IHC vs ICC vs IF: Differences in Immunolabeling Techniques
What Are IHC, ICC, and IF?
Immunohistochemistry (IHC), immunocytochemistry (ICC), and immunofluorescence (IF) are closely related techniques that use antibodies to detect antigens in biological samples. Scientists refer to this process as immunolabeling, a term derived from the immune response that generates antibodies.
Although these methods share a common foundation, they describe different aspects of how samples are labeled and analyzed. Understanding these distinctions is essential for selecting the appropriate method and interpreting results accurately.
What Is Immunolabeling?
Immunolabeling is the process of using antibodies to detect specific antigens, most often proteins. However, antibodies can also be generated against other molecular targets.
There are two primary approaches to immunolabeling. In direct labeling, a reporter molecule is conjugated directly to the primary antibody. In indirect labeling, a secondary antibody carries the reporter and binds to the primary antibody.

Figure 1. Direct immunolabeling uses primary antibodies that are conjugated to reporter molecules. Indirect immunolabeling uses reporter-conjugated secondary antibodies.
Researchers use several types of reporters in these methods, including chromogenic enzymes, metal nanoparticles such as immunogold, and fluorescent molecules. Each approach offers distinct advantages depending on the experimental goal.
Chromogenic Immunolabeling
Chromogenic immunolabeling uses enzyme-conjugated secondary antibodies (horseradish peroxidase, HRP, or alkaline phosphatase, AP) to convert chromogenic substrates into colored precipitates at the site of antigen binding. Labeled tissues are visualized using transmitted light microscopy. Vector Laboratories sells a number of substrates that are oxidized by HRP or hydrolyzed by AP into different colored precipitates for multiplexing. Chromogenic methods are good for long-term slide storage, but the degree of multiplexing is limited (Figure 2). The common enzyme assay ELISA is also based on chromogenic immunolabeling with a colored, water-soluble reaction product.

Figure 2. Composite image of all 4 chromogens (PSMA, CD8, basal cell and P504S) plus hematoxylin to produce 5-color brightfield (transmittance) representation of prostate tumor FFPE tissue. Used under CC by 4 license without modification from (Morrison, 2025) Figure 6c.
Immunogold Labeling
Immunogold labeling was developed primarily for use in transmission electron microscopy (TEM) for mapping sub-cellular components. The secondary antibody is conjugated to a gold nanoparticle which shows up as a black dot in the TEM image. Limited multiplexing can be achieved by using nanoparticles of different sizes. Gold conjugated antibodies are available from Aurion. Gold conjugated antibodies are also widely used in lateral flow immunoassays (e.g. COVID test). A variant of this method called silver-enhanced immunogold labeling uses the gold nanoparticle as a silver nucleation site to increase the particle size enough to be detected using transmitted light microscopy.
Methods using transmitted light for detection suffer from lower sensitivity and fewer multiplexing opportunities than the more widely used immunofluorescence methods.
Immunofluorescence (IF)
Describes the method that uses antibodies to fluorescently label compounds of interest. As with immunolabeling broadly, fluorescent reporters can be attached to either the primary antibody (direct IF) or a secondary antibody (indirect IF). Direct IF has the advantage of less background and non-specific staining, but fewer fluorophores per antibody. Indirect IF tends to have higher background signal with more fluorophores per antibody.
IF has advantages over colorimetric techniques because of the high sensitivity and dynamic range achieved when detecting emission signals in a dark background. Because the background is dark, high levels of multiplexing are possible (Figure 3). Signals from different fluorophores can be separated using a combination of lasers, filters and cyclic staining strategies.
IF is commonly used in fluorescence microscopy, fluorescent Western blotting, flow cytometry and fluorescence immunoassays.
Immunohistochemistry (IHC)
Is used to characterize the chemical distribution and makeup of tissues (histology). Traditional (clinical) histology uses H&E (hematoxylin and eosin) absorptive stains to label nuclei (blue/purple) and proteins (pink). After fixation (either flash frozen or formalin fixed paraffin embedded – FFPE), very thin (<5 micron) slices are made, stained and analyzed with light microscopy. Chromogenic immunolabeling can be paired with H&E staining on the same or adjacent slices. The sample prep for chromogenic IHC and H&E staining is identical.

Figure 3. Multiplexed IF IHC of a 10 micron thick rat brain slice imaged with widefield epifluorescence. Used under CC by 4 license without modification from (Maric, 2021) Figure 6a.
IHC Sample Preparation and Imaging
Samples are generally much thicker for IF IHC because of its sensitivity. Depending on the fluorescence microscopy method, slices can range from <20 micron thick for widefield epifluorescence to 1 mm for multiphoton microscopy and even thicker for light sheet microscopy with tissue clearing. The thicker samples provide much more detail about three-dimensional structure than the very thin slices required for chromogenic methods.
Immunocytochemistry (ICC)
Is used to characterize the chemical distribution and makeup of individual cells (cytology). It is often performed on cell suspensions including cell lines, blood and other bodily fluids, algae, etc. (cover photo) Chromogenic immunolabeling is less common for ICC, but immunogold labeling is relatively common for characterizing cellular ultrastructure. IF ICC opens more pathways for analysis including flow cytometry and sorting of suspended cells and advanced fluorescence microscopy methods including super-resolution techniques (PALM, STORM, STED, etc.). IF ICC has the unique ability to label surface markers on live cells, or the cells can be fixed and permeabilized for intracellular labeling.
ICC Applications and Flexibility
Although IF, IHC and ICC are often used as interchangeable terms, they are distinct concepts. IF describes the labeling and detection method, while IHC and ICC describe the sample type and labeling method, but not the detection method. One can infer whether IHC and ICC experiments are IF or chromogenic by the experimental setup (flow cytometry, fluorescence microscopy or transmitted light microscopy), but for clarity, it’s best to explicitly state one or the other.
Key Differences Between IHC, ICC, and IF
Although IHC, ICC, and IF are often used interchangeably, they represent distinct concepts. IF refers to the detection method, specifically fluorescence-based labeling. In contrast, IHC and ICC describe the type of sample being analyzed—tissue or individual cells, respectively.
In practice, the experimental setup often determines whether fluorescence or chromogenic detection is used. However, for clarity, researchers should explicitly state both the sample type and detection method when describing their experiments.
Conclusion
IHC, ICC, and IF are foundational techniques in immunolabeling, each serving a distinct role in biological analysis. While IF defines how targets are detected, IHC and ICC define the context in which those targets are studied.
Understanding these differences allows researchers to select the appropriate method, design more effective experiments, and interpret results with greater confidence.
References
Maric (2021). doi:10.1038/s41467-021-21735-x
Morrison (2025). doi:10.3390/diagnostics15020164